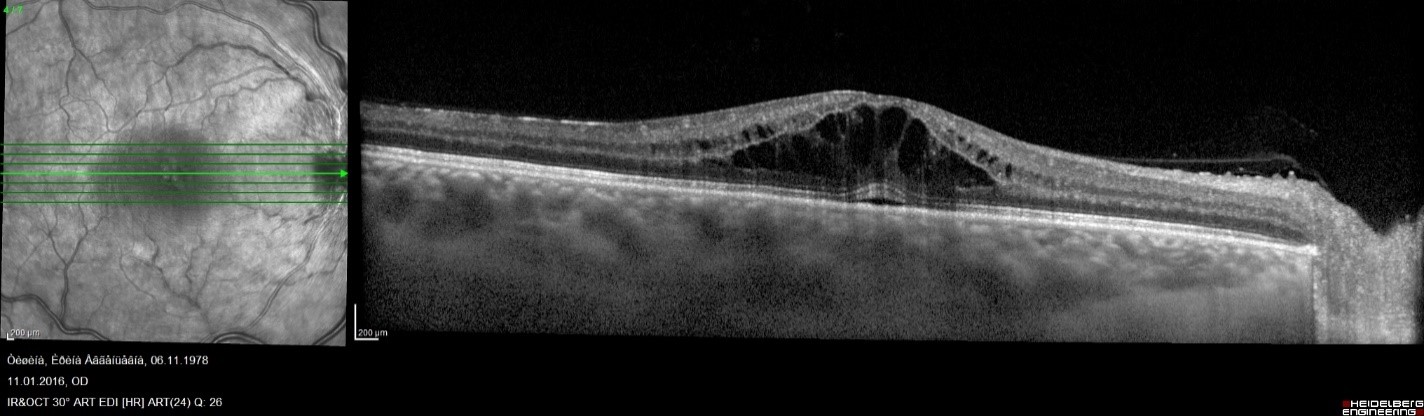

Окклюзия вен сетчатки (ОВС) занимает второе место по распространенности после диабетической ретинопатии среди сосудистой ретинальной патологии. В настоящее время 28,06 млн человек во всем мире страдает ОВС. ОВС - возраст-ассоциированное заболевание, более 90% случаев возникает у лиц старше 55 лет, но, к сожалению, встречается и в более молодом возрасте. Наиболее часто пациенты знают эту патологию под названием тромбоз (непроходимость) вены или вен сетчатки.
К основным факторам риска ОВС относят артериальную гипертензию, дислипидемию (нарушение обмена холестерина и других жиров с нарушением их нормального соотношения в крови) и гипергомоцистеинемию.
Кроме того, наличие заболеваний, сопровождающиеся повышенной вязкостью крови (макроглобулинемия, миеломная болезнь, полицитемия, антифосфолипидный синдром), а также тромбофилии (резистентность фактора V в активированному протеину С, дефицит протеина С, S, антитромбина, XII фактора, мутация в гене протромбина), также повышают риск ОВС. У лиц молодого возраста имеют значение воспалительные заболевания (болезнь Бехчета, саркоидоз, гранулематоз с полиангиитом).
В основе развития ОВС является изменение артериальной стенки, возникающее с возрастом, при артериальной гипертензии, дислипидемии, при которых артериальная стенка теряет свою эластичность, значительно увеличивается ее жесткость, что в свою очередь может вызвать компрессию подлежащей вены, предрасполагая к развитию ее окклюзии (непроходимости).
Классификация ОВС основана на локализации окклюзии. Согласно ей выделяют: окклюзию центральной вены сетчатки, окклюзию ветвей центральной вены сетчатки и гемицентральную ретинальную окклюзию. В зависимости от тяжести патологического процесса, которая определяется сохранностью капиллярной перфузии, ОВС подразделяют на ишемический и неишемический тип.
Основной жалобой при ОВС является внезапное, безболезненное снижение зрение на одном глазу, которому могут предшествовать периодическое затуманивание зрения. К другим симптомам относятся искажение предметов и «темное пятно» перед глазом.
Диагноз ОВС устанавливают на основе осмотра глазного дна (офтальмоскопии), при которой выявляются расширенные, извитые вены и разнокалиберные геморрагии (кровоизлияния). В ряде случаев обнаруживают т.н. ватные экссудаты и отек сетчатки в центральной зоне (макулярный отек).
Обязательным методом обследования при обнаружении нарушения проходимости вен сетчатки является выполнение оптической когерентой томографии сетчатки (ОКТ) для оценки витреоретинального интерфейса, толщины и микроструктуры сетчатки в макулярной области, так как в 60-100% окклюзии центральной вены сетчатки и в 10% - ее ветвей, осложняются развитием макулярного отека.
Для дифференциации типа окклюзии применяется флюоресцентная ангиография сетчатки, позволяющая оценить площадь неперфузируемой сетчатки. Оценка степени ишемии крайне важна, так как риск неоваскулярных осложнений (т.е. осложнений, возникающих вследствие роста новообразованных сосудов, имеющих нарушенную структуру стенки), пропорционален степени отсутствия капиллярной перфузии.
Для изучения перфузии в макулярной области и на средней периферии сетчатки возможно использование ОКТ-ангиографии. Этот бесконтактный метод обследования позволяет визуализировать четыре капиллярных сплетения с количественным анализом микроциркуляции.
Важным преимуществом ОКТ-ангиографии является неинвазивность исследования, при которой, в отличие от флюоресцентной ангиографии, не требуется внутривенного введения контрастного вещества. Однако, в ряде случаев, уточнение характера заболевания требует проведения обоих методов обследования.

Общепринятой тактики лечения ОВС нет, но в период оказания неотложной помощи необходимо попытаться как можно быстрее восстановить проходить пораженной вены с помощью субконъюнктивального или интравитреального (в область стекловидного тела) введения тромболитиков. Однако, эти средства возможно использовать не позднее 14 дня с момента начала заболевания. В дальнейшем проводят симптоматическую терапию, направленную на борьбу с макулярным отеком и предотвращение развития неоваскулярных осложнений.
Препаратами первого выбора для лечения посттромботического макулярного отека являются ингибиторы ангиогенеза, к которым относятся афлиберцепт, ранибизумаб. Их эффективность и безопасность подтверждена многоцентровыми, рандомизированными клиническими исследованиями – BRAVO, CRUISE, CRYSTAL, BRIGHTER, GALILEO, COPERNICUS, VIBRANT.
При наличии макулярного отека рекомендовано выполнение ежемесячных интравитреальных инъекций до достижения максимально возможной остроты зрения при отсутствии признаков активности заболевания. Для этого необходимо проведение трех и более последовательных ежемесячных инъекций с последующим наблюдением и выполнением инъекций или в режиме «pro re nata», или «treat and extend».
Препаратом второй линии терапии является глюкокортикостероид пролонгированного действия - Озурдекс - биодеградируемый имплантат для интравитреального введения.
Вопрос о сроках выполнения лазерной коагуляции при ишемическом типе окклюзии остается до сих пор предметов дискуссии. Ретинальная неоваскуляризация сетчатки или развитие неоваскулярной глаукомы являются абсолютными показанием для выполнения панретинальной лазерной коагуляции сетчатки. Некоторыми авторами было выявлено, что проведение профилактической лазерной коагуляции сетчатки в зонах отсутствия капиллярной перфузии уменьшает риски развития неоваскулярных осложнений и количество рецидивов макулярного отека.
Для профилактики реокклюзии на пораженном глазу, развития ОВС на парном глазу и развития других (системных) тромбоэмболических состояний необходимо выявление и коррекция основных факторов риска заболевания. Пациентам необходимо проведение комплексного обследования, включая коагулограмму, липидограмму, определение уровня гомоцистеина, суточное мониторирование артериального давления с оценкой индекса ночного апноэ, ультразвуковое дуплексное сканирование брахиоцефальных сосудов, а при отсутствии системных факторов риска – молекулярно-генетическое типирование системы гемостаза. При выявлении патологии крайне важно наблюдение у специалиста соответствующего профиля.
В офтальмологическом центре «ОФТАКОН ЭКСПЕРТ» пациенты с сосудистой патологией органа зрения могут получить консультацию высококлассных врачей-офтальмологов, специализирующихся на лечении больных с различной патологией сетчатки, пройти полноценное комплексное обследование, включая биомикроофтальмоскопию с высокодиоптрийными линзами, ОСТ, ОСТ-ангиографию, офтальмотонометрию (измерение внутриглазного давления), компьютерную периметрию и ряд других методов, необходимых в каждом конкретном случае.